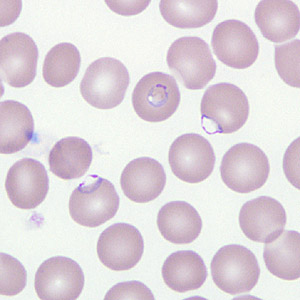
Case266_D.jpg
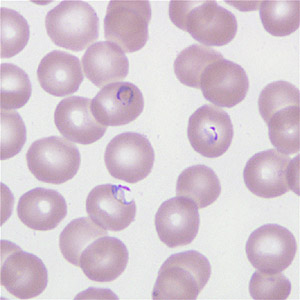
Case266_E.jpg
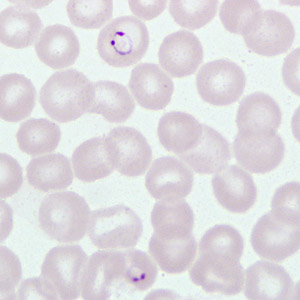

Case #266 – December, 2009
A 40-year-old man sought medical attention at a hospital one week after returning from a mining operation in Ghana. He presented with diarrhea, vomiting, and night fevers. Although not confirmed, it was assumed that he did not take any anti-malarial prophylaxis. Two sets of thick and thin blood smears were made, one set of which was stained with Wright-Giemsa. Both the stained and unstained smears were sent to the CDC for diagnostic assistance. Figures A–E show what was observed on the pre-stained thin smear in moderate numbers. What is your diagnosis? Based on what criteria?

Figure A

Figure B

Figure C
Figure D
Figure E

Figure F
Images presented in the DPDx case studies are from specimens submitted for diagnosis or archiving. On rare occasions, clinical histories given may be partly fictitious.
DPDx is an educational resource designed for health professionals and laboratory scientists. For an overview including prevention, control, and treatment visit www.cdc.gov/parasites/.